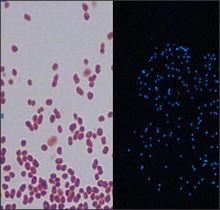
革蘭氏染色後發光菌對比暗室中菌落髮光

現身市場
 夜明豬
夜明豬早在2007年,就有媒體報導過西安曾發現類似的螢光豬肉。當時,有專家出來解釋說,發光現象表示肉品沒有腐敗,若肉品長時間存放,發光現象就會消失,但也表明肉品開始變質,發光豬肉只要煮熟、煮透便可以放心食用。2007年,在湖南長沙等地,又陸續發現了這種“藍光豬肉”。
對“藍光豬肉”,各方說法不一。有人認為是豬肉本身存在某種有毒物質,是生豬養殖環節的問題。有人認為是超市銷售或物流過程保管不當,還有的認為可能是消費者購買和存放過程中污染所致。
2011年4月初,陳女士在楊高北路的一家菜場買了2斤豬肉。當晚家人一起包餃子,用了一部分豬肉。隨後,她把剩下的肉放在廚房的小桌上。夜裡11點,陳女士起床準備上洗手間,突然看見廚房方向有隱約的藍光,打開燈後卻沒見到異樣。陳女士再次將燈關掉,藍光再次出現,她壯著膽子走過去,伸手一摸,發現軟軟的,原來是豬肉。陳女士一開始以為是光線問題,於是把豬肉提起來,在黑暗中走動。她發現,瑩瑩的藍光跟著豬肉動。隨後,她仔細盯著豬肉看,發現是肉在發光。 12月4日左右,家住北京的李先生在居住地附近的菜市場買了一塊豬肉,肉看上去無任何異狀。李先生回憶,12月7日晚,他將原本掛在廚房的豬肉提進了臥室,“怕貓偷吃”。不想,到了8日凌晨5點多,準備起床的李先生被掛在臥室的豬肉嚇了一跳。“牆邊藍瑩瑩的一片,朦朦朧朧的,很瘮人,我嚇得趕緊開燈,燈亮了,發光處只有那塊豬肉在那兒掛著。”李先生重新關燈,才發現發出藍光的正是那塊豬肉。
樣品檢測
湖南師範大學生命科學院微生物系鄧樂教授在實驗室里對豬肉上所存在的微生物細胞做了細菌切片,透過顯微鏡看到各種形狀的細菌密密麻麻排列在一起,並通過紫外透射反射儀清楚的看到豬肉表面發出的條狀綠螢光。
鄧教授稱,全世界有100多種發螢光的桿菌,但絕大多數都存在於海洋之中,因為這種桿菌需要約3%的鹽分才適宜它生長。它在肉質品上出現,有沒有毒性?即它對人體有沒有危害還需要做毒理試驗,通常大多數桿菌通過蒸炒的高溫都能夠將其殺死,但也不排除一些形成芽孢的桿菌,如霍亂弧菌等需要一百多度高溫才能殺滅。
鄧教授建議市民不必引起恐慌,但建議儘量少吃。
事件調查
2010年3月,據長沙市委宣傳部有關人士介紹,長沙“藍光豬肉”事件發生後,當地政府要求,必須本著對老百姓菜籃子高度負責的態度,對市場上出現的發光肉展開認真調查。
長沙市食品安全委員會辦公室綜合協調組副組長姚喜琳稱,圍繞“藍光豬肉”,長沙市食品安全委員會統一部署,商務、畜牧、工商、衛生等部門組織力量,同時邀請專家教授參加,一是對生豬養殖、屠宰、運輸、存貯、銷售等環節進行監督檢查和檢驗檢測;二是對城區63家超市、117個農貿市場、4個定點屠宰場、1個外來肉品市場進行檢驗檢測,抽樣245份,其中豬肉樣品155份、環境樣品90份。
根據民眾舉報,長沙有媒體在城郊接合部發現了採用飯店泔水養豬的養豬場。這些衛生條件差的養豬場餵豬的泔水中,有含磷餐廚廢棄物及洗滌劑。這種豬場出欄的生豬通過一些地下渠道流入市場。這讓人懷疑,泔水污染導致豬肉中含磷高而發光。 但監管部門發現,出現“藍光豬肉”的超市進貨渠道正規,貨源經過嚴格檢驗檢疫。
官方說法
細菌感染
在2010年“3.15”前夕,長沙市食品安全委員會辦公室綜合協調組副組長姚喜琳介紹,經過為期10天的檢測,專家發現有7份豬肉樣品、1份環境樣品培養分離出發光細菌,均出自家樂福超市芙蓉店。檢測結果表明,家樂福超市芙蓉店豬肉發光是豬肉表面污染髮光細菌所致,系進貨後的環境因素造成的二次污染。
根據檢測結果,長沙市食品安全委員會組織商務、畜牧、工商等部門責成家樂福超市芙蓉店暫停散包裝豬肉的銷售,對超市記憶體貯、銷售環境全面清洗消毒,經省、市畜禽檢驗檢測中心檢測合格後,再行恢復銷售。
長沙市食品安全委員會通報說,根據湖南省、市檢驗檢測機構以及有關專家研究分析,發光細菌在自然界廣泛存在,屬於低溫菌,發光蛋白本身無毒性,農業部已公布的動物傳染病一、二、三類名錄中均未列入此類發光細菌。截至2010年3月,國內外尚未發現有關發光細菌對人體造成危害的情況。
長沙市有關方面表示,今後將組織相關職能部門對全市大型超市、農貿市場、定點屠宰企業等肉品經銷場所進行不定期檢查,要求經營單位對環境進行全面淨化消毒,以防類似情況再次發生。
飼料過量
2011年12月12日,北京市通州區動物檢驗檢疫所工作人員表示,螢光豬肉很可能是生豬在飼養環節即被餵食過過量含磷飼料,導致豬體內磷含量超標,“也可能是這塊豬肉感染了細菌,有一種螢光菌,如果豬肉在切割中沾上這種菌,菌的代謝物就會讓豬肉發出藍色螢光。”
專家研究
革蘭氏染色後發光菌對比暗室中菌落髮光
革蘭氏染色後發光菌對比暗室中菌落髮光湖南研究人員從污染豬肉中分離到一株發光菌,通過形態和培養特徵的觀察、生化特徵研究及基因序列分析,對菌株進行了鑑定。 根據研究結論,這種發光菌為,最適合生長的溫度為18-22 °C。一般情況只在含鹽培養基上生長,提示該菌可能來源於海洋,但只要營養條件合適,這種菌也可以在低鹽或無鹽的狀態下良好生長。 “急性致病試驗”顯示,發光桿菌對小白鼠沒有明顯的致病性,試驗組小鼠均未出現體溫升高及死亡現象,但在一定條件下,發光菌在肌體內可持續生存。
研究結果表明,這種發光菌對鏈黴素、磺胺、環丙沙星等多種抗菌藥物敏感;新潔爾滅、乙醇等常用消毒劑能殺死該菌。
事件影響
市民關注
隨著“發光豬肉”的不斷出現,不少市民對食品安全的關注達到了前所未有的高度。
2010年3月2日,在華聲論壇的混在長沙版塊,一個叫“親親飛天貓”的網友在民生版塊發帖,題為《 大家一起抵制家樂福發光豬肉!》,幾個小時內該帖點擊量破千。
網友“bobo1257”:“收檢查費的職能部門兩隻手都數不過來,豬肉出問題了竟然沒有一個部門能出來吭一聲,是不敢說還是不願意說?老百姓的食品安全誰來監管?”
網友“讓說話嗎”:“為什麼食品安全問題出現這么久了,職能部門只會‘踢皮球’,現在讓草根們用網路的力量來呼籲抵制來減少誤傷,這不是一種悲哀嗎?”
律師說法
湖南金州律師事務所的陳平凡律師認為:根據中國《食品安全法》及其實施條例、《流通環節食品安全監督管理辦法》、《食品衛生監督程式》等法律法規,如果食品確實存在問題的話,應予以停止銷售並進行召回,啟動食品檢測程式。
食品經營者應當建立並執行食品退市制度。食品經營者發現其經營的食品不符合食品安全標準,應當立即停止經營,下架單獨存放,通知相關生產經營者和消費者。
假若放任不符合安全標準的食品投入流通的,並造成重大食品安全事故的,食品生產者、銷售者、運輸者、食品檢驗機構、縣級以上衛生行政、農業行政、質量監督、工商行政管理、食品藥品監督管理部門或者其他有關行政部門均可能承擔輕則罰款、重則撤職、開除的行政、民事處罰,情節特別嚴重者還需承擔相應刑事責任。
不宜食用
2011年12月11日,食品衛生專家董金獅分析,豬肉發出螢光,很可能是有不法分子在豬的肥肉部分塗上了螢光增白劑,“這種方法能讓肥肉看起來更白,賣相更好。普通水洗,肥肉上的螢光劑不容易去掉。”
董金獅稱,如果排除“人工增白”可能,就只可能是豬肉沾染了螢光菌,“在自然界,出現天然螢光的現象並不鮮見,比如蘑菇和竹子,都會出現天然螢光,這其實都是螢光菌的作用。”
董金獅認為,由於目前暫不清楚豬肉上出現的螢光究竟是何物,“無論是人為還是沾了螢光菌,這種豬肉都不宜食用,因為螢光增白物質一旦超標,會影響人體健康。”董金獅說。

